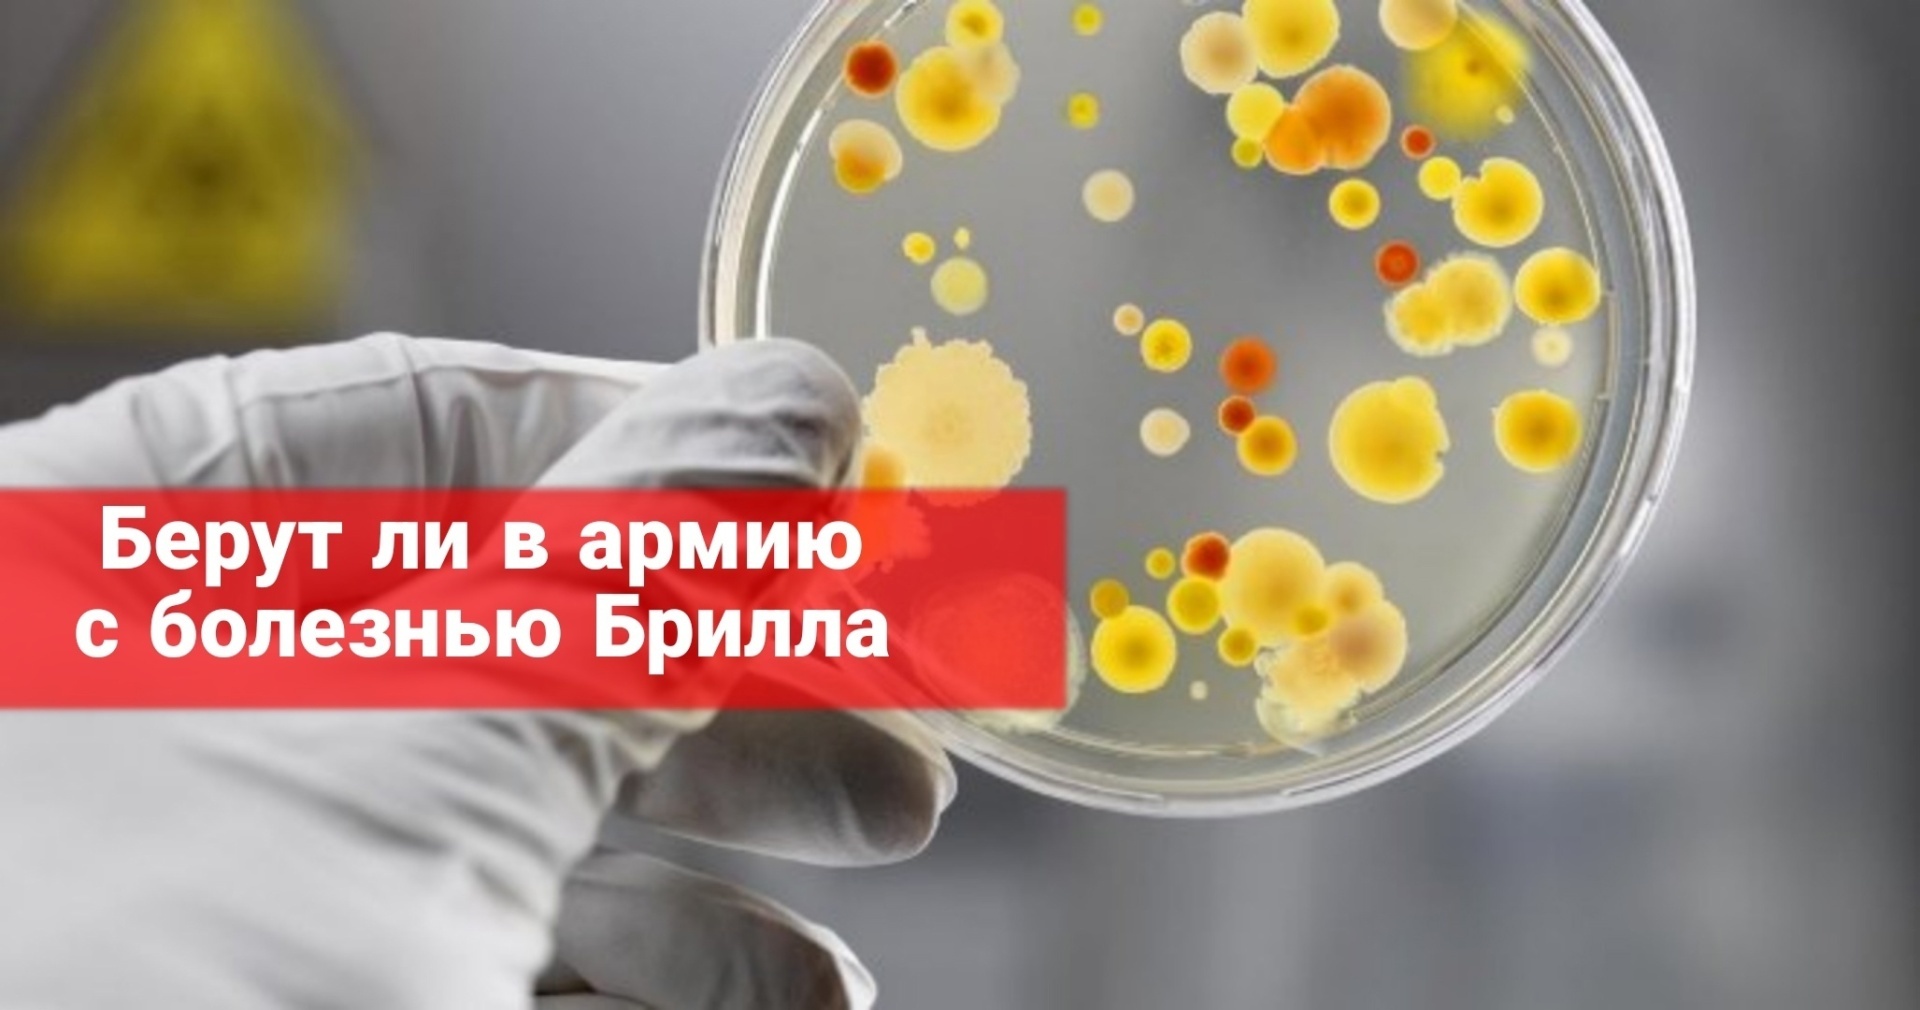
Берут ли в армию с болезнью Брилла

Берут ли в армию с болезнью Брилла
Болезнь Брилла – рецидивное состояние сыпного тифа, при котором сохраняются клинические признаки первичной болезни.
Течение болезни легче.
Главное клиническое проявление – наличие обильной розеолезно-петехиальной сыпи на кожных покровах и слизистых оболочках.
Причиной возникновения рецидива является инфекция риккетсии, запустить процесс возможно при переохлаждении, респираторных инфекциях, стрессовых ситуациях и другое.
Болезнь не стоит игнорировать, так как помимо сыпных проявлений, она может влиять на разные системы органов, например на сердце – бородавчатый эндокардит, головной мозг – ишемические процессы.
Симптомы.
Заболевание может протекать от 3 до 50 лет, его начало, как правило, острое – резкий подъем температуры вплоть до 39 градусов, озноб, сильная слабость, головная боль, нарушение сна, эйфория, снижение давления, гиперемия лица, пятна Авцына ( единичные красно-оранжевые элементы с нечетким контуром на конъюнктиве, хряще верхнего века), энантема Розенберга (небольшие петехии на мягком небе, дужках и миндалинах).
Примерно на 3-4 день на коже образуется сыпь без зуда.
Призывник с болезнью Брилла не освобождается от службы в армии, согласно статье 1 Расписания болезней, ему назначается категория «Г» (отсрочка) на 6 месяцев для прохождения лечения.
В случае проявления осложнений, медицинское освидетельствование будет проходить по ним.
Если у вас возникли вопросы по теме данной публикации, вы всегда можете написать мне в мессенджеры или позвонить: